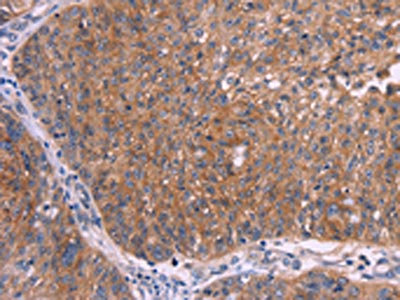

EMP2 Antibody
-
中文名稱:EMP2兔多克隆抗體
-
貨號:CSB-PA447792
-
規格:¥1100
-
圖片:
-
The image on the left is immunohistochemistry of paraffin-embedded Human thyroid cancer tissue using CSB-PA447792(EMP2 Antibody) at dilution 1/30, on the right is treated with synthetic peptide. (Original magnification: ×200)
-
The image on the left is immunohistochemistry of paraffin-embedded Human ovarian cancer tissue using CSB-PA447792(EMP2 Antibody) at dilution 1/30, on the right is treated with synthetic peptide. (Original magnification: ×200)
-
-
其他:
產品詳情
-
Uniprot No.:
-
基因名:EMP2
-
別名:EMP2; XMP; Epithelial membrane protein 2; EMP-2; Protein XMP
-
宿主:Rabbit
-
反應種屬:Human
-
免疫原:Synthetic peptide of Human EMP2
-
免疫原種屬:Homo sapiens (Human)
-
標記方式:Non-conjugated
-
抗體亞型:IgG
-
純化方式:Antigen affinity purification
-
濃度:It differs from different batches. Please contact us to confirm it.
-
保存緩沖液:-20°C, pH7.4 PBS, 0.05% NaN3, 40% Glycerol
-
產品提供形式:Liquid
-
應用范圍:ELISA,IHC
-
推薦稀釋比:
Application Recommended Dilution ELISA 1:2000-1:5000 IHC 1:50-1:200 -
Protocols:
-
儲存條件:Upon receipt, store at -20°C or -80°C. Avoid repeated freeze.
-
貨期:Basically, we can dispatch the products out in 1-3 working days after receiving your orders. Delivery time maybe differs from different purchasing way or location, please kindly consult your local distributors for specific delivery time.
-
用途:For Research Use Only. Not for use in diagnostic or therapeutic procedures.
相關產品
靶點詳情
-
功能:Functions as a key regulator of cell membrane composition by regulating proteins surface expression. Also, plays a role in regulation of processes including cell migration, cell proliferation, cell contraction and cell adhesion. Negatively regulates caveolae formation by reducing CAV1 expression and CAV1 amount by increasing lysosomal degradation. Facilitates surface trafficking and formation of lipid rafts bearing GPI-anchor proteins. Regulates surface expression of MHC1 and ICAM1 proteins increasing susceptibility to T-cell mediated cytotoxicity. Regulates the plasma membrane expression of the integrin heterodimers ITGA6-ITGB1, ITGA5-ITGB3 and ITGA5-ITGB1 resulting in modulation of cell-matrix adhesion. Also regulates many processes through PTK2. Regulates blood vessel endothelial cell migration and angiogenesis by regulating VEGF protein expression through PTK2 activation. Regulates cell migration and cell contraction through PTK2 and SRC activation. Regulates focal adhesion density, F-actin conformation and cell adhesion capacity through interaction with PTK2. Positively regulates cell proliferation. Plays a role during cell death and cell blebbing. Promotes angiogenesis and vasculogenesis through induction of VEGFA via a HIF1A-dependent pathway. Also plays a role in embryo implantation by regulating surface trafficking of integrin heterodimer ITGA5-ITGB3. May play a role in glomerular filtration.
-
基因功能參考文獻:
- It is a biomarker in gliomas and may have use as a molecular target for the diagnosis and treatment of gliomas. PMID: 28887715
- High EMP2 expression is associated with endometrial cancer. PMID: 28604744
- Experiments in vitro using human trophoblast cells lines indicate that EMP2 modulates angiogenesis by altering HIF-1alpha expression. The results reveal a novel role for EMP2 in regulating trophoblast function and vascular development in mice and humans, and suggest that it may be a new biomarker for placental insufficiency. PMID: 28295343
- All studied ERMs and PVR membranes express EMP2. Levels of EMP2 trended higher in all PVR subgroups than in ERMs, especially in inflammatory and traumatic PVR. PMID: 27294805
- a novel SNP x SNP interaction between rs2267668 in PPARdelta and rs7191411 in EMP2 that has significant impact on circulating HDL-C levels in the Singaporean Chinese population. PMID: 27530449
- These results support that loss of EMP2 is common, and its re-expression may serve as an approach to enhance radiation sensitivity in nasopharyngeal carcinoma. PMID: 28347228
- Data show that loss of epithelial membrane protein 2 (EMP2) is involved in sphingosylphosphorylcholine (SPC)-induced phosphorylation of keratin 8 (K8) via ubiquitination of protein phosphatase 2 (PP2A) through alpha4 phosphoprotein by caveolin-1 (cav-1). PMID: 26876307
- EMP2 plays a tumor suppressor role by inducing G2/M cell cycle arrest, suppressing cell viability, proliferation, colony formation/ anchorage-independent cell growth via regulation of G2/M checkpoints in distinct-derived cell lines. PMID: 25940704
- Loss of EMP2 is associated with nasopharyngeal carcinoma. PMID: 25684502
- the role of EMP2 in the pathogenesis of GBM a PMID: 24644285
- We showed that knockdown of EMP2 in podocytes and endothelial cells resulted in an increased amount of CAVEOLIN-1 and decreased cell proliferation, so EMP2 mutations causes a recessive Mendelian form of steroid-sensitive nephrotic syndrome. PMID: 24814193
- EMP2 was identified as a tumor-suppressor gene in urinary tract urothelial carcinoma. PMID: 23838430
- support the role of EMP2 in the control of the tumor microenvironment and confirm the cytotoxic effects observed by EMP2 treatment in vivo PMID: 23334331
- Manipulation of EMP2 levels in endometrial cancer cells regulates the phosphorylation of FAK and Src, and promotes their distribution into lipid raft domains. PMID: 21637765
- EMP2 is expressed in the majority of ovarian tumors and may be a feasible target in vivo. PMID: 20670949
- evaluation as candidate gene for Charcot-Marie-Tooth disease type 1C on chromosome 16p PMID: 11713717
- This protein is expressed in discrete anatomical regions of the eye. PMID: 12710941
- EMP2 induces alphavbeta3 surface expression. PMID: 16216233
- These findings identify EMP2 as a candidate host protein involved in infection of Chlamydia muridarum. [EMP-2] PMID: 17544801
- EMP2 regulates caveolin-1 transcription and more substantially its protein levels. PMID: 17609206
- Targeting of EMP2 to specific locations under the influence of these steroid hormones may be important for integrating the molecular responses required for implantation competence. PMID: 18400107
- EMP2 may be a potential pharmacologic target for human endometrial cancer. PMID: 19010852
顯示更多
收起更多
-
相關疾病:Nephrotic syndrome 10 (NPHS10)
-
亞細胞定位:Golgi apparatus membrane; Multi-pass membrane protein. Cell membrane. Apical cell membrane. Membrane raft. Cytoplasm. Nucleus.
-
蛋白家族:PMP-22/EMP/MP20 family
-
組織特異性:Expressed in ciliary body epithelia, sclera, cornea, and retinal pigment epithelium (at protein level).
-
數據庫鏈接:
Most popular with customers
-
-
YWHAB Recombinant Monoclonal Antibody
Applications: ELISA, WB, IHC, IF, FC
Species Reactivity: Human, Mouse, Rat
-
-
-
-
-
-